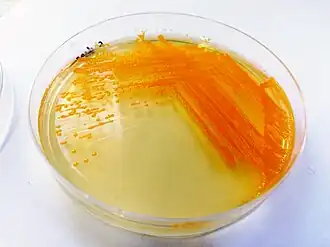

Chryseobacterium
| Chryseobacterium | ||||||||||||
|---|---|---|---|---|---|---|---|---|---|---|---|---|
Chryseobacterium oleae | ||||||||||||
| Systematik | ||||||||||||
| ||||||||||||
| Wissenschaftlicher Name | ||||||||||||
| Chryseobacterium | ||||||||||||
| Vandamme et al. (1994) |
Chryseobacterium ist eine Gattung von Bakterien. Der Gattungsname besteht aus dem lateinischen Wort bacterium und dem griechischen Wort chryseos, was so viel wie „golden“ bedeutet und auf die Farbe der einzelnen Kolonien deutet.
Merkmale
Die Zellen der verschiedenen Arten von Chryseobacterium sind meist ca. 0,5 µm breit, die Länge liegt meist im Bereich von 1 bis 3 µm[1]. Auch pleomorphe und filamentöse Formen treten auf. Endosporen werden nicht gebildet.
Die meisten Stämme wachsen optimal bei Temperaturen zwischen 15 und 30 °C, pH-Werten von 6–8 und 0–1 % Natriumchlorid, einige tolerieren auch höhere NaCl-Gehalte (halotolerant).
Die Kolonien können, je nach Art, Farben von schwachen Gelb bis zu ausgeprägtem Orange aufweisen, was an Flexirubin-ähnlichen Pigmenten liegt. Einige Arten bilden auch Carotinoide, wie z. B. Chryseobacterium bovis.[2] Die Bakterien sind unbeweglich, auch eine gleitende Bewegung (gliding motility), die bei vielen verwandten Arten der Familie Flavobacteriales beobachtet wird, tritt nicht auf.[1] Der Katalasetest und der Oxidase-Test verläuft positiv. Nitrat wird von den meisten Arten nicht zu Nitrit reduziert. Die meisten Arten sind aerob, einige Arten zeigen auch anaerobischen Stoffwechsel mit Nitrat als den terminalen Elektronenakzeptor. Hierzu zählen Chryseobacterium gleum und C. indologenes.[3][4] Menachinon-6 (MK-6) ist das dominierende Menachinon.[1] Die Unterart Chryseobacterium aquaticum subsp. greenlandense wurde im Gröndlandeis im Jahr 2010 in einer Tiefe von 3042 Meter gefunden.[5] Bei den Zellen handelt es sich um extrem kleine Stäbchen mit 0,6–1,2 µm Länge und Breiten zwischen 0,4 und 0,5 µm. Das Bakterium toleriert extrem niedrige Temperaturen, hohen Druck und zeigt nur unter geringen Sauerstoffgehalt (microaerophil) Wachstum. Aufgrund dessen ist das Bakterium auch für die Astrobiologie von Interesse, da z. B. auf dem Jupitermond Europa (Mond) unter einer mehreren Kilometer dicken Eisschicht ähnliche Bedingungen herrschen könnten. Zuerst wurde dem Bakterium eine eigene Art zugeschrieben und unter dem Namen Chryseobacterium greenlandenseis geführt. Aufgrund weiterer genetischer Untersuchungen wurde es im Jahr 2020 als Unterart zu Chryseobacterium aquaticum gestellt.[6]
Systematik
Die Gattung Chryseobacterium wurde aus sechs Arten der Gattung Flavobacterium im Jahr 1994 gegründet. Diese Arten unterscheiden sich klar von der Typusart Flavobacterium aquatile.[7] Es handelt sich um die Arten: Chryseobacterium balustinum, C. gleum, C. indologenes, C. indoltheticum, C. meningosepticum und C. scophthalmum. Als Typusart wurde Chryseobacterium gleum (zuvor als Flavobacterium gleum geführt) gewählt. Die Art Chryseobacterium meningosepticum (King 1959) Vandamme et al. 1994 wurde im Jahr 2005 zu der neu erstellten Gattung Elizabethkingia verschoben.[8] Chryseobacterium wurde 2020 der neu aufgestellten Familie Weeksellaceae zugeordnet. Im Dezember 2021 waren über 100 Arten bekannt. Es folgt eine Auswahl der in der Gattung geführten Arten (Juli 2018):[9]
- Chryseobacterium aahli Loch and Faisal 2014
- Chryseobacterium angstadtii Kirk et al. 2013
- Chryseobacterium antarcticum (Yi et al. 2005) Kämpfer et al. 2009
- Chryseobacterium anthropi Kämpfer et al. 2009
- Chryseobacterium aquaticum Kim et al. 2008
- Chryseobacterium arthrosphaerae Kämpfer et al. 2010
- Chryseobacterium artocarpi Venil et al. 2014
- Chryseobacterium balustinum (Harrison 1929) Vandamme et al. 1994
- Chryseobacterium bernardetii Holmes et al. 2013
- Chryseobacterium bovis Hantsis-Zacharov et al. 2008
- Chryseobacterium contaminans Kämpfer et al. 2014
- Chryseobacterium cucumeris Jeong et al. 2017
- Chryseobacterium elymi Cho et al. 2011
- Chryseobacterium flavum Zhou et al. 2007
- Chryseobacterium gallinarum Kämpfer et al. 2014
- Chryseobacterium glaciei Pal et al. 2018
- Chryseobacterium gleum (Holmes et al. 1984) Vandamme et al. 1994
- Chryseobacterium hagamense Cho et al. 2011
- Chryseobacterium indologenes (Yabuuchi et al. 1983) Vandamme et al. 1994
- Chryseobacterium jejuense Weon et al. 2008
- Chryseobacterium kwangjuense Sang et al. 2013
- Chryseobacterium pallidum Herzog et al. 2008
- Chryseobacterium scophthalmum (Mudarris et al. 1994) Vandamme et al. 1994
- Chryseobacterium taiwanense Tai et al. 2006
- Chryseobacterium vietnamense Li and Zhu 2012
Medizin
Die Art Chryseobacterium indologenes kann im Krankenhaus über betroffene Inkubator-, Respirator-, Vernebler und Waschflüssigkeiten bereits erkrankte und somit immungeschwächte Menschen befallen. C. indologenes ist, wie auch die in früher der gleichen Gattung stehende Art Elizabethkingia meningoseptica, im Allgemeinen resistent gegen die in der Regel bei gramnegativen Bakterien genutzten Antibiotika (z. B. β-Lactame). Einsetzbar sind Trimethoprim-Sulfamethoxazol, Rifampicin und Gyrasehemmer.[10]
Einzelnachweise
- ↑ a b c Michael Goodfellow u. a. (Hrsg.): Bergey’s Manual of Systematic Bacteriology. 2. Auflage, Band 5: The Bacteroidetes, Spirochaetes, Tenericutes (Mollicutes), Acidobacteria, Fibrobacteres, Fusobacteria, Dictyoglomi, Gemmatimonadetes, Lentisphaerae, Verrucomicrobia, Chlamydiae, and Planctomycetes. Springer, New York 2012, ISBN 978-0-387-95042-6.
- ↑ Bergey's Manual of Systematics of Archaea and Bacteria. 1. Auflage. Wiley, 2015, ISBN 978-1-118-96060-8, doi:10.1002/9781118960608.gbm00301.pub2 (wiley.com [abgerufen am 23. Juni 2024]).
- ↑ B. Holmes, R. J. Owen, T. A. McMeekin: Genus Flavobacterium. In: Bergey’s Manual of Systematic Bacteriology. 1. Auflage, Band 1: Gram-negative Bacteria of general, medical, or industrial importance. Williams & Wilkins, Baltimore 1984, S. 353–361.
- ↑ B. Holmes u. a.: Flavobacterium gleum, a new species found in human clinical specimens. In: International Journal of Systematic Bacteriology, Band 34, 1984, Nr. 1, S. 21–25. doi:10.1099/00207713-34-1-21
- ↑ Jennifer Loveland-Curtze, Vanya Miteva, Jean Brenchley: Novel ultramicrobacterial isolates from a deep Greenland ice core represent a proposed new species, Chryseobacterium greenlandense sp. nov. In: Extremophiles. 14, 2010, S. 61–69, doi:10.1007/s00792-009-0287-6.
- ↑ García López et al.: Analysis of 1,000 Type-Strain Genomes Improves Taxonomic Classification of Bacteroidetes. In: Frontiers in Microbioly (2019). Ausgabe 10, S. 2083. doi:10.3389/fmicb.2019.02083
- ↑ P. Vandamme u. a.: New perspectives in the classification of the Flavobacteria: description of Chryseobacterium gen. nov., Bergeyella gen. nov., and Empedobacter nom. Rev. In: International Journal of Systematic Bacteriology, Band 44, Nr. 4, S. 827–831. doi:10.1099/00207713-44-4-827
- ↑ Kwang Kyu Kim, Myung Kyum Kim, Ju Hyoung Lim, Hye Yoon Park & Sung-Taik Lee: Transfer of Chryseobacterium meningosepticum and Chryseobacterium miricola to Elizabethkingia gen. nov. as Elizabethkingia meningoseptica comb. nov. and Elizabethkingia miricola comb. nov. International Journal of Systematic and Evolutionary Microbiology, 2005, Band 55, S. 1287–1293. doi:10.1099/ijs.0.63541-0
- ↑ Systematik nach: J.P. Euzéby: List of Prokaryotic names with Standing in Nomenclature (LPSN) -Chryseobacterium (Stand: 17. Juli 2018)
- ↑ Gholamreza Darai u. a.: Lexikon der Infektionskrankheiten des Menschen: Erreger, Symptome, Diagnose, Therapie und Prophylaxe. Springer, New York 2003, ISBN 978-3-540-44168-7.
Literatur
- Michael Goodfellow u. a. (Hrsg.): Bergey’s Manual of Systematic Bacteriology. 2. Auflage, Band 5: The Bacteroidetes, Spirochaetes, Tenericutes (Mollicutes), Acidobacteria, Fibrobacteres, Fusobacteria, Dictyoglomi, Gemmatimonadetes, Lentisphaerae, Verrucomicrobia, Chlamydiae, and Planctomycetes. Springer, New York 2012, ISBN 978-0-387-95042-6.
Weblinks
- J. P. Euzéby: List of Prokaryotic names with Standing in Nomenclature (LPSN) Gattung: Chryseobacterium
- Chryseobacterium indologenes auf Microbe-Wiki